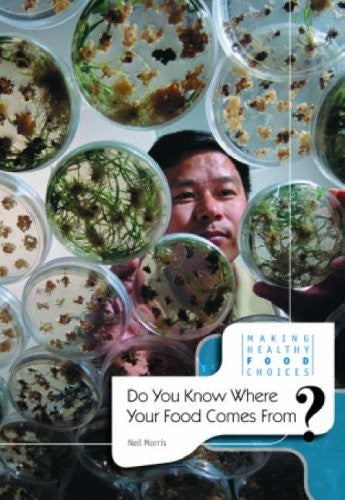

Do You Know Where Your Food Comes From?
Summary
The feel-good place to buy books
Do You Know Where Your Food Comes From? by Neil Morris
The food we choose affects people's lives and the environment. This book shows how the global food market is affecting all of us. Case studies, recipes, and fascinating facts help make this book useful and engaging to students.
Neil Morris is an experienced writer on children's topics. He has been a contributor to dictionaries and encyclopedias. His recent work includes 'What Has Space Exploration Done for Us?', a guide to researching the Industrial Revolution, and a review of the impact of environmentalism on the landscape.
| SKU | Unavailable |
| ISBN 13 | 9780431119175 |
| ISBN 10 | 0431119171 |
| Title | Do You Know Where Your Food Comes From? |
| Author | Neil Morris |
| Series | Making Healthy Food Choices |
| Condition | Unavailable |
| Binding Type | Hardback |
| Publisher | Capstone Global Library Ltd |
| Year published | 2006-10-19 |
| Number of pages | 56 |
| Cover note | Book picture is for illustrative purposes only, actual binding, cover or edition may vary. |
| Note | Unavailable |